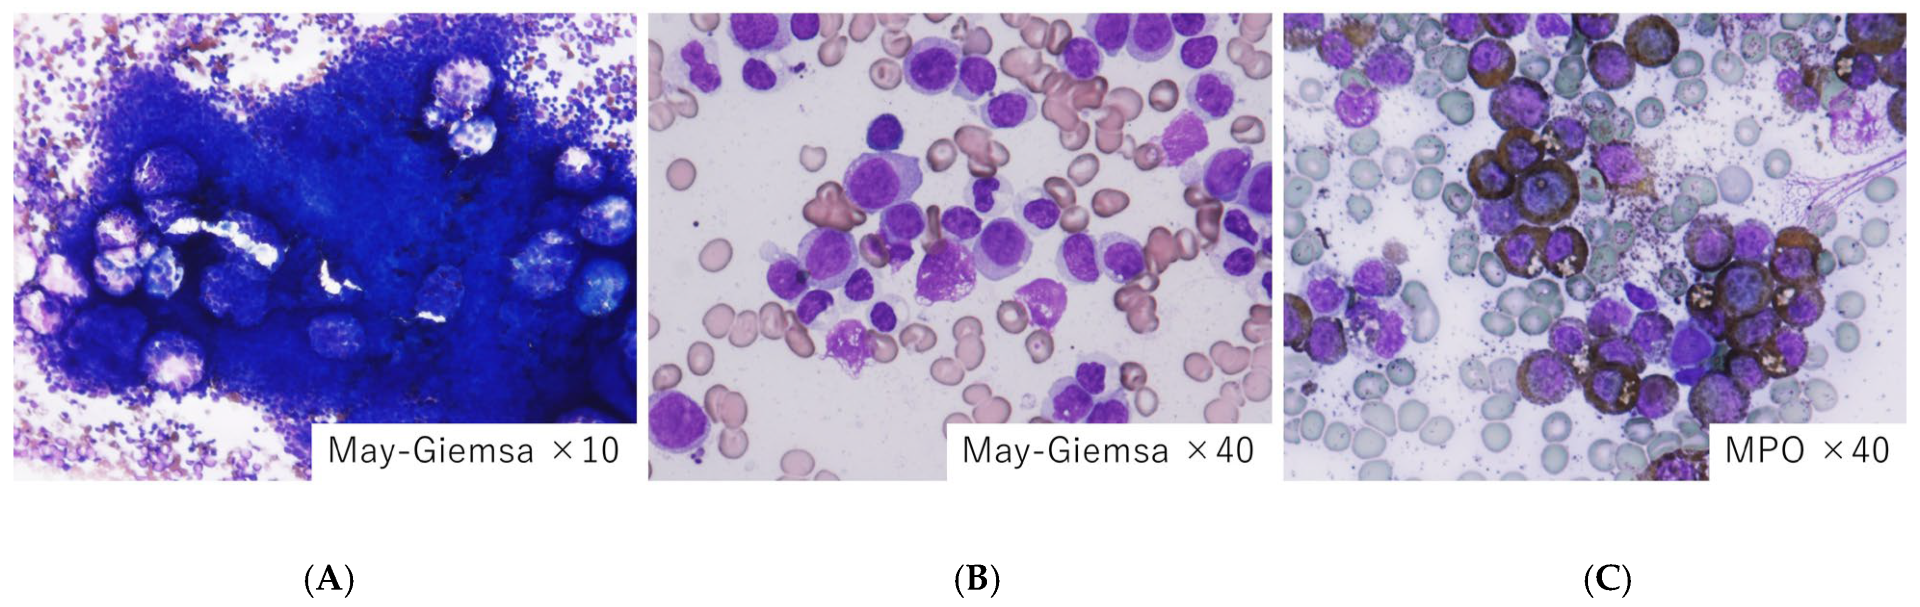

Characteristics of Myelodysplastic Syndrome with Coagulation Abnormalities and Tailored Diagnosis and Treatment
Abstract
1. Introduction
2. Pathogenic Mechanism
3. Disseminated Intravascular Coagulation (DIC)
4. Tumor Lysis Syndrome (TLS)
5. Infection
6. Thromboembolism
- (1)
- Abnormal blood cells: MDS involves dysfunctional blood cell production, including abnormal red blood cells, white blood cells, and platelets. These abnormal cells can contribute to clot formation.
- (2)
- Bone marrow dysfunction: MDS affects the bone marrow, leading to ineffective hematopoiesis. This can result in abnormal blood cell components that increase the risk of clotting.
- (3)
- Cytokine dysregulation: In MDS, abnormal cytokine production can lead to inflammation and activation of the coagulation system, promoting clot formation.
- (4)
- Age and comorbidities: MDS is more common in older adults, and age itself is a risk factor for thromboembolism. Additionally, comorbidities (such as cardiovascular disease) may further elevate the risk.
- (5)
- Blood transfusions and chemotherapy: Some MDS patients receive blood transfusions or chemotherapy, both of which can increase the risk of thromboembolism.
- (6)
- Coagulation disorder state: The combination of abnormal blood cells, inflammation, and other factors creates a hypercoagulable state, making clot formation more likely.
7. Hemophagocytic Syndrome/Hemophagocytic Lymphohistiocytosis (HPS/HLH)
8. Hemorrhage and Hematoma Formation
9. Leukemoid Reaction
10. Differentiate Secondary Causes from Primary Causes
11. Conclusions
Author Contributions
Funding
Institutional Review Board Statement
Informed Consent Statement
Data Availability Statement
Conflicts of Interest
Abbreviations
| MDS | Myelodysplastic syndrome |
| MDS-MLD | Myelodysplastic syndrome with multilineage dysplasia |
| DIC | Disseminated intravascular coagulation |
| LDH | Lactate dehydrogenase |
| MCP-1 | Monocyte chemotactic protein-1 |
| mTOR | Mammalian target of rapamycin |
| NF-kB | Nuclear factor kappa-light-chain-enhancer of activated B cells |
| PI3K | Phoinositide 3-kinase |
| TF | Tissue factor |
| TLR | Toll-like receptor |
| TLS | Tumor lysis syndrome |
| HPS/HLH | Hemophagocytic syndrome/hemophagocytic lymphohistiocytosis |
| PNS | Paraneoplastic syndrome |
| PNSs | Paraneoplastic syndromes |
| SDS | Shwachman–Diamond syndrome |
| VEXAS | Vacuoles, E1 enzyme, X-linked, autoinflammatory, somatic |
References
- Cazzola, M. Myelodysplastic Syndromes. N. Engl. J. Med. 2020, 383, 1358–1374. [Google Scholar] [CrossRef] [PubMed]
- Kantarjian, H.; Giles, F.; List, A.; Lyons, R.; Sekeres, M.A.; Pierce, S.; Deuson, R.; Leveque, J. The incidence and impact of thrombocytopenia in myelodysplastic syndromes. Cancer 2007, 109, 1705–1714. [Google Scholar] [CrossRef] [PubMed]
- Taylor, F.B., Jr.; Toh, C.H.; Hoots, W.K.; Wada, H.; Levi, M.; Scientific Subcommittee on Disseminated Intravascular Coagulation (DIC) of the International Society on Thrombosis and Haemostasis (ISTH). Towards definition, clinical and laboratory criteria, and a scoring system for disseminated intravascular coagulation. Thromb. Haemost. 2001, 86, 1327–1330. [Google Scholar] [CrossRef] [PubMed]
- Galera, P.; Dulau-Florea, A.; Calvo, K.R. Inherited thrombocytopenia and platelet disorders with germline predisposition to myeloid neoplasia. Int. J. Lab. Hematol. 2019, 41 (Suppl. S1), 131–141. [Google Scholar] [CrossRef] [PubMed]
- Luu, S.; Gardiner, E.E.; Andrews, R.K. Bone Marrow Defects and Platelet Function: A Focus on MDS and CLL. Cancers 2018, 10, 147. [Google Scholar] [CrossRef] [PubMed] [PubMed Central]
- Mittelman, M.; Zeidman, A. Platelet function in the myelodysplastic syndromes. Int. J. Hematol. 2000, 71, 95–98. [Google Scholar] [PubMed]
- Martín, M.; de Paz, R.; Jiménez-Yuste, V.; Fernández Bello, I.; García Arias Salgado, E.; Alvarez, M.T.; Butta, N.V. Platelet apoptosis and agonist-mediated activation in myelodysplastic syndromes. Thromb. Haemost. 2013, 109, 909–919. [Google Scholar] [CrossRef] [PubMed]
- Girtovitis, F.I.; Ntaios, G.; Papadopoulos, A.; Ioannidis, G.; Makris, P.E. Defective platelet aggregation in myelodysplastic syndromes. Acta Haematol. 2007, 118, 117–122. [Google Scholar] [CrossRef] [PubMed]
- Liu, J.; Niu, H.; Yue, L.; Lv, Q.; Yang, L.; Liu, C.; Jiang, H.; Xing, L.; Shao, Z.; Wang, H. Abnormal platelet phenotypes in patients with myelodysplastic syndromes. Int. J. Lab. Hematol. 2020, 42, 371–379. [Google Scholar] [CrossRef] [PubMed]
- Wu, Y.F.; Gu, M.H.; Liu, C.Z.; Huang, W.H.; Chu, S.C.; Wang, T.F. Abnormal platelet immunophenotypes and percentage of giant platelets in myelodysplastic syndrome: A pilot study. PLoS ONE. 2022, 17, e0278040. [Google Scholar] [CrossRef] [PubMed] [PubMed Central]
- Sandes, A.F.; Yamamoto, M.; Matarraz, S.; Chauffaille Mde, L.; Quijano, S.; López, A.; Oguro, T.; Kimura, E.Y.; Orfao, A. Altered immunophenotypic features of peripheral blood platelets in myelodysplastic syndromes. Haematologica 2012, 97, 895–902. [Google Scholar] [CrossRef] [PubMed] [PubMed Central]
- Fernández Bello, I.; Jiménez-Yuste, V.; de Paz, R.; Martín Salces, M.; Justo Sanz, R.; Monzón Manzano, E.; Arias-Salgado, E.G.; Álvarez Román, M.T.; Rivas Pollmar, M.I.; Goyanes, I.; et al. Factors Involved in Maintaining Haemostasis in Patients with Myelodysplastic Syndrome. Thromb. Haemost. 2018, 118, 734–744. [Google Scholar] [CrossRef] [PubMed]
- Biss, T.; Crossman, L.; Neilly, I.; Hanley, J. An acquired factor VIII inhibitor in association with a myeloproliferative/myelodysplastic disorder presenting with severe subcutaneous haemorrhage. Haemophilia 2003, 9, 638–641. [Google Scholar] [CrossRef] [PubMed]
- Psaila, B.; Bussel, J.B.; Frelinger, A.L.; Babula, B.; Linden, M.D.; Li, Y.; Barnard, M.R.; Tate, C.; Feldman, E.J.; Michelson, A.D. Differences in platelet function in patients with acute myeloid leukemia and myelodysplasia compared to equally thrombocytopenic patients with immune thrombocytopenia. J. Thromb. Haemost. 2011, 9, 2302–2310. [Google Scholar] [CrossRef] [PubMed] [PubMed Central]
- Guédon, A.F. VEXAS syndrome: From a vascular perspective. Blood 2024, 143, 2118–2120. [Google Scholar] [CrossRef] [PubMed]
- Beck, D.B.; Ferrada, M.A.; Sikora, K.A.; Ombrello, A.K.; Collins, J.C.; Pei, W.; Balanda, N.; Ross, D.L.; Ospina Cardona, D.; Wu, Z.; et al. Somatic Mutations in UBA1 and Severe Adult-Onset Autoinflammatory Disease. N. Engl. J. Med. 2020, 383, 2628–2638. [Google Scholar] [CrossRef] [PubMed] [PubMed Central]
- Libourel, E.J.; Klerk, C.P.W.; van Norden, Y.; de Maat, M.P.M.; Kruip, M.J.; Sonneveld, P.; Löwenberg, B.; Leebeek, F.W.G. Disseminated intravascular coagulation at diagnosis is a strong predictor for thrombosis in acute myeloid leukemia. Blood 2016, 128, 1854–1861. [Google Scholar] [CrossRef] [PubMed]
- Martella, F.; Cerrano, M.; Di Cuonzo, D.; Secreto, C.; Olivi, M.; Apolito, V.; D’Ardia, S.; Frairia, C.; Giai, V.; Lanzarone, G.; et al. Frequency and risk factors for thrombosis in acute myeloid leukemia and high-risk myelodysplastic syndromes treated with intensive chemotherapy: A two centers observational study. Ann. Hematol. 2022, 101, 855–867. [Google Scholar] [CrossRef] [PubMed]
- Acosta, A.; Venkatesh, S.; Elfessi, Z. Spontaneous tumor lysis syndrome in the setting of Candida albicans Fungemia. Am. J. Emerg. Med. 2023, 67, 195.e5–195.e6. [Google Scholar] [CrossRef] [PubMed]
- Sagou, K.; Ito, M.; Kawamura, Y.; Ukai, S.; Goto, M.; Fukushima, N.; Ozeki, K.; Fukuyama, R.; Kohno, A. Severe tumor lysis syndrome during the induction therapy for the treatment of blastic plasmacytoid dendritic cell neoplasm arising from myelodysplastic/myeloproliferative neoplasms. Clin. Case Rep. 2020, 9, 878–882. [Google Scholar] [CrossRef] [PubMed] [PubMed Central]
- Jasek, A.M.; Day, H.J. Acute spontaneous tumor lysis syndrome. Am. J. Hematol. 1994, 47, 129–131. [Google Scholar] [CrossRef] [PubMed]
- Cohen, L.F.; Balow, J.E.; Magrath, I.T.; Poplack, D.G.; Ziegler, J.L. Acute tumor lysis syndrome. A review of 37 patients with Burkitt's lymphoma. Am. J. Med. 1980, 68, 486–491. [Google Scholar] [CrossRef] [PubMed]
- Hsu, H.H.; Chen, Y.C.; Tian, Y.C.; Chan, Y.L.; Kuo, M.C.; Tang, C.C.; Fang, J.T.; Lee, S.Y.; Yang, C.W. Role of serum sodium in assessing hospital mortality in cancer patients with spontaneous tumour lysis syndrome inducing acute uric acid nephropathy. Int. J. Clin. Pract. 2009, 63, 751–756. [Google Scholar] [CrossRef] [PubMed]
- Cairo, M.S.; Bishop, M. Tumour lysis syndrome: New therapeutic strategies and classification. Br. J. Haematol. 2004, 127, 3–11. [Google Scholar] [CrossRef] [PubMed]
- Feng, Y.; Jiang, T.; Wang, L. Hyperuricemia and acute kidney injury secondary to spontaneous tumor lysis syndrome in low risk myelodysplastic syndrome. BMC Nephrol. 2014, 15, 164. [Google Scholar] [CrossRef] [PubMed] [PubMed Central][Green Version]
- Pomeroy, C.; Oken, M.M.; Rydell, R.E.; Filice, G.A. Infection in the myelodysplastic syndromes. Am. J. Med. 1991, 90, 338–344. [Google Scholar] [CrossRef] [PubMed]
- Fianchi, L.; Leone, G.; Posteraro, B.; Sanguinetti, M.; Guidi, F.; Valentini, C.G.; Voso, M.T.; Pagano, L. Impaired bactericidal and fungicidal activities of neutrophils in patients with myelodysplastic syndrome. Leuk. Res. 2012, 36, 331–333. [Google Scholar] [CrossRef] [PubMed]
- Sullivan, L.R.; Sekeres, M.A.; Shrestha, N.K.; Maciejewski, J.P.; Tiu, R.V.; Butler, R.; Mossad, S.B. Epidemiology and risk factors for infections in myelodysplastic syndromes. Transpl. Infect. Dis. 2013, 15, 652–657. [Google Scholar] [CrossRef] [PubMed]
- Mądry, K.; Lis, K.; Fenaux, P.; Bowen, D.; Symeonidis, A.; Mittelman, M.; Stauder, R.; Čermák, J.; Sanz, G.; Hellström-Lindberg, E.; et al. Cause of death and excess mortality in patients with lower-risk myelodysplastic syndromes (MDS): A report from the European MDS registry. Br. J. Haematol. 2023, 200, 451–461. [Google Scholar] [CrossRef] [PubMed]
- Girmenia, C.; Candoni, A.; Delia, M.; Latagliata, R.; Molteni, A.; Oliva, E.N.; Palumbo, G.A.; Poloni, A.; Salutari, P.; Santini, V.; et al. Infection control in patients with myelodysplastic syndromes who are candidates for active treatment: Expert panel consensus-based recommendations. Blood Rev. 2019, 34, 16–25. [Google Scholar] [CrossRef] [PubMed]
- Alkharabsheh, O.A.; Saadeh, S.S.; Zblewski, D.L.; Gangat, N.; Begna, K.H.; Elliott, M.A.; Alkhateeb, H.B.; Patnaik, M.S.; Hogan, W.J.; Litzow, M.R.; et al. Frequency of venous thrombotic events in patients with myelodysplastic syndrome and 5q deletion syndrome during lenalidomide therapy. Ann. Hematol. 2019, 98, 331–337. [Google Scholar] [CrossRef] [PubMed]
- Park, S.; Fenaux, P.; Greenberg, P.; Mehta, B.; Callaghan, F.; Kim, C.; Tomita, D.; Xu, H. Efficacy and safety of darbepoetin alpha in patients with myelodysplastic syndromes: A systematic review and meta-analysis. Br. J. Haematol. 2016, 174, 730–747. [Google Scholar] [CrossRef] [PubMed] [PubMed Central]
- Du, X.L.; Zhang, Y.; Hardy, D. Associations between hematopoietic growth factors and risks of venous thromboembolism, stroke, ischemic heart disease and myelodysplastic syndrome: Findings from a large population-based cohort of women with breast cancer. Cancer Causes Control 2016, 27, 695–707. [Google Scholar] [CrossRef] [PubMed]
- Platzbecker, U.; Symeonidis, A.; Oliva, E.N.; Goede, J.S.; Delforge, M.; Mayer, J.; Slama, B.; Badre, S.; Gasal, E.; Mehta, B.; et al. A phase 3 randomized placebo-controlled trial of darbepoetin alfa in patients with anemia and lower-risk myelodysplastic syndromes. Leukemia 2017, 31, 1944–1950. [Google Scholar] [CrossRef] [PubMed] [PubMed Central]
- Brunner, A.M.; Weng, S.; Cronin, A.; Fathi, A.T.; Habib, A.R.; Stone, R.; Graubert, T.; Steensma, D.P.; Abel, G.A. Impact of lenalidomide use among non-transfusion dependent patients with myelodysplastic syndromes. Am. J. Hematol. 2018, 93, 1119–1126. [Google Scholar] [CrossRef] [PubMed]
- Falanga, A.; Ay, C.; Di Nisio, M.; Gerotziafas, G.; Jara-Palomares, L.; Langer, F.; Lecumberri, R.; Mandala, M.; Maraveyas, A.; Pabinger, I.; et al. Venous thromboembolism in cancer patients: ESMO Clinical Practice Guideline. Ann. Oncol. 2023, 34, 452–467. [Google Scholar] [CrossRef] [PubMed]
- Tsuji, T.; Yamasaki, H.; Arima, N.; Tsuda, H. Hemophagocytic lymphohistiocytosis associated with myelodysplastic syndromes. Int. J. Hematol. 2010, 92, 547–549. [Google Scholar] [CrossRef] [PubMed]
- Sun, Y.; Blieden, C.; Merritt, B.Y.; Sosa, R.; Rivero, G. Hemophagocytic lymphohistiocytosis and myelodysplastic syndrome: A case report and review of the literature. J. Med. Case Rep. 2021, 15, 98. [Google Scholar] [CrossRef] [PubMed] [PubMed Central]
- Daitoku, S.; Aoyagi, T.; Takao, S.; Tada, S.; Kuroiwa, M. Successful treatment of hemophagocytic lymphohistiocytosis associated with low-risk myelodysplastic syndrome by azacitidine. Intern. Med. 2018, 57, 2995–2999. [Google Scholar] [CrossRef]
- Kim, S.H.; Yi, D.Y.; Lee, N.M.; Yun, S.W.; Chae, S.A.; Lim, I.S. A rare case of hemophagocytic lymphohistiocytosis associated with myelodysplastic syndrome and trisomy 8 in a pediatric patient. J. Pediatr. Hematol. Oncol. 2019, 41, 57–59. [Google Scholar] [CrossRef]
- Malliah, R.B.; Chang, V.T.; Choe, J.K. Infection-associated haemophagocytic syndrome associated with recurrent acute myeloid leukaemia/myelodysplastic syndrome: An autopsy case. J. Clin. Pathol. 2007, 60, 431–433. [Google Scholar] [CrossRef] [PubMed] [PubMed Central]
- Wang, H.; Xiong, L.; Tang, W.; Zhou, Y.; Li, F. A systematic review of malignancy-associated hemophagocytic lymphohistiocytosis that needs more attentions. Oncotarget 2017, 8, 59977–59985. [Google Scholar] [CrossRef] [PubMed] [PubMed Central]
- Gholam, C.; Grigoriadou, S.; Gilmour, K.C.; Gaspar, H.B. Familial haemophagocytic lymphohistiocytosis: Advances in the genetic basis, diagnosis and management. Clin. Exp. Immunol. 2011, 163, 271–283. [Google Scholar] [CrossRef] [PubMed] [PubMed Central]
- Fenaux, P.; Platzbecker, U.; Ades, L. How we manage adults with myelodysplastic syndrome. Br. J. Haematol. 2020, 189, 1016–1027. [Google Scholar] [CrossRef] [PubMed]
- Foy, P.; Friedman, K.D.; Michaelis, L.C. How I diagnose and treat thrombocytopenia in geriatric patients. Blood 2024, 143, 214–223. [Google Scholar] [CrossRef] [PubMed]
- Waisbren, J.; Dinner, S.; Altman, J.; Frankfurt, O.; Helenowski, I.; Gao, J.; McMahon, B.J.; Stein, B.L. Disease characteristics and prognosis of myelodysplastic syndrome presenting with isolated thrombocytopenia. Int. J. Hematol. 2017, 105, 44–51. [Google Scholar] [CrossRef] [PubMed]
- Menke, D.M.; Colon-Otero, G.; Cockerill, K.J.; Jenkins, R.B.; Noel, P.; Pierre, R.V. Refractory thrombocytopenia. A myelodysplastic syndrome that may mimic immune thrombocytopenic purpura. Am. J. Clin. Pathol. 1992, 98, 502–510. [Google Scholar] [CrossRef] [PubMed]
- Greenberg, P.L.; Tuechler, H.; Schanz, J.; Sanz, G.; Garcia-Manero, G.; Solé, F.; Bennett, J.M.; Bowen, D.; Fenaux, P.; Dreyfus, F.; et al. Revised international prognostic scoring system for myelodysplastic syndromes. Blood 2012, 120, 2454–2465. [Google Scholar] [CrossRef] [PubMed] [PubMed Central]
- Boettcher, S.; Manz, M.G. Regulation of Inflammation- and Infection-Driven Hematopoiesis. Trends Immunol. 2017, 38, 345–357. [Google Scholar] [CrossRef] [PubMed]
- Trowbridge, J.J.; Starczynowski, D.T. Innate immune pathways and inflammation in hematopoietic aging, clonal hematopoiesis, and MDS. J. Exp. Med. 2021, 218, e20201544. [Google Scholar] [CrossRef] [PubMed] [PubMed Central]
- Byrne, M.; Liu, X.; Carter, C.M.; Zumberg, M.S. Myelodysplastic syndrome and associated coagulopathy: A case report and review. Blood Coagul. Fibrinolysis 2014, 25, 172–175. [Google Scholar] [CrossRef] [PubMed]
- Maurya, N.; Mohanty, P.; Panchal, P.; Shanmukhaiah, C.; Vundinti, B.R. Over expression of mTOR gene predicts overall survival in myelodysplastic syndromes. Mol. Biol. Rep. 2023, 50, 235–244. [Google Scholar] [CrossRef] [PubMed]
- Han, X.; Lu, S.; Gu, C.; Bian, Z.; Xie, X.; Qiao, X. Clinical features, epidemiology, and treatment of Shwachman-Diamond syndrome: A systematic review. BMC Pediatr. 2023, 23, 503. [Google Scholar] [CrossRef] [PubMed] [PubMed Central]
- Sabbioni, G.; D’Aversa, E.; Breveglieri, G.; Altieri, M.T.; Boni, C.; Pegoraro, A.; Finotti, A.; Gambari, R.; D’Amico, G.; Vella, A.; et al. Constitutive systemic inflammation in Shwachman-Diamond Syndrome. Mol. Med. 2025, 31, 81. [Google Scholar] [CrossRef] [PubMed] [PubMed Central]
- Gando, S.; Levi, M.; Toh, C.H. Disseminated intravascular coagulation. J. Intensive Care 2025, 13, 32. [Google Scholar] [CrossRef] [PubMed] [PubMed Central]

| Category | Primary Coagulopathy | Secondary Coagulopathy |
|---|---|---|
| Initiating mechanism | Intrinsic platelet dysfunction; dysregulated fibrinolysis linked to clonal hematopoiesis | Triggered by systemic processes like infection, DIC, TLS, HPS/HLH, and bleeding |
| Key cytokines | IL-6, TNF-α, and IL-1β Impact on megakaryopoiesis; clotting protein expression | IL-8, MCP-1, and IL-10 Systemic inflammation; endothelial activation |
| Signaling pathways | JAK-STAT: dysregulated in pre-MDS and CHIP mTOR: impairs platelet granule release | TLR/NF-κB: activated in infection PI3K/AKT: amplified in TLS TF pathway: endothelial/tumor cell activation |
| Paraneoplastic involvement | Coagulopathy as a direct PNS manifestation, independent of systemic triggers | Coagulopathy as part of broader secondary syndromes (e.g., DIC due to sepsis or bleeding) |
| Fibrinolytic behavior | Primary hyperfibrinolysis; abnormal plasmin generation | Secondary fibrinolysis disturbance from hepatic dysfunction; consumptive coagulopathy |
| Platelet function | Intrinsic thrombocytopathy: abnormal receptor expression, impaired aggregation | Quantitative platelet loss or dysfunction due to marrow suppression or peripheral consumption |
| Laboratory findings | Normal fibrinogen Prolonged APTT/PT Low aggregation Normal D-dimer | ↓ Fibrinogen ↑ D-dimer ↑ Schistocytes due to hemolysis ↓ Platelets due to consumption |
| Therapeutic focus | Modulation of intrinsic pathways: mTOR, cytokines; transfusion is often insufficient | Addressing underlying disease (infection, TLS); supportive care with fresh plasma or anticoagulants if thrombotic component is present |
Disclaimer/Publisher’s Note: The statements, opinions and data contained in all publications are solely those of the individual author(s) and contributor(s) and not of MDPI and/or the editor(s). MDPI and/or the editor(s) disclaim responsibility for any injury to people or property resulting from any ideas, methods, instructions or products referred to in the content. |
© 2025 by the authors. Licensee MDPI, Basel, Switzerland. This article is an open access article distributed under the terms and conditions of the Creative Commons Attribution (CC BY) license (https://creativecommons.org/licenses/by/4.0/).
Share and Cite
Imataki, O.; Uemura, M.; Kitanaka, A. Characteristics of Myelodysplastic Syndrome with Coagulation Abnormalities and Tailored Diagnosis and Treatment. J. Pers. Med. 2025, 15, 429. https://doi.org/10.3390/jpm15090429
Imataki O, Uemura M, Kitanaka A. Characteristics of Myelodysplastic Syndrome with Coagulation Abnormalities and Tailored Diagnosis and Treatment. Journal of Personalized Medicine. 2025; 15(9):429. https://doi.org/10.3390/jpm15090429
Chicago/Turabian StyleImataki, Osamu, Makiko Uemura, and Akira Kitanaka. 2025. "Characteristics of Myelodysplastic Syndrome with Coagulation Abnormalities and Tailored Diagnosis and Treatment" Journal of Personalized Medicine 15, no. 9: 429. https://doi.org/10.3390/jpm15090429
APA StyleImataki, O., Uemura, M., & Kitanaka, A. (2025). Characteristics of Myelodysplastic Syndrome with Coagulation Abnormalities and Tailored Diagnosis and Treatment. Journal of Personalized Medicine, 15(9), 429. https://doi.org/10.3390/jpm15090429

